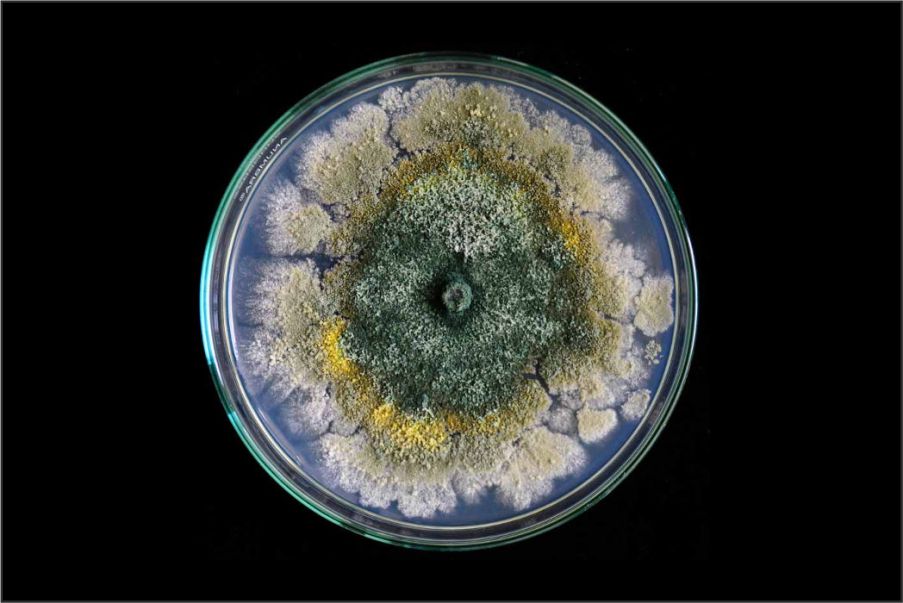

TITLE
Efficacy of Slow Sand Filtration Enriched with Trichoderma atroviride in the Control of Fusarium oxysporum in Soilless Cultivation Systems
JOURNAL
Pathogens
AUTHORS
Pedro Matias, Luisa Coelho, Mário Reis
ABSTRACT
On a planet intending to move toward carbon neutrality while ensuring food security, maximizing water and nutrient use efficiency in agriculture is essential. Soilless cultivation offers a promising solution for food production, yet in substrate-based systems, excess nutrient solution (drainage) is often discarded to maintain phytosanitary safety, resulting in considerable water and nutrient waste. Reusing this drainage requires disinfection to eliminate pathogens. Among available methods, slow sand filtration (SSF) is ecological, economical, and simple, showing strong biological control potential, though not always fully effective against Fusarium oxysporum. Trichoderma atroviride, an antagonistic fungus, may enhance SSF performance. Its antagonistic capacity was evaluated in vitro via direct confrontation assays and in vivo using a closed-loop soilless cucumber cultivation system with eight treatment combinations of SSF, T. atroviride, and F. oxysporum. SSF reduced F. oxysporum incidence by approximately 48%, T. atroviride in irrigation by 44%, and SSF enriched with T. atroviride reached 58% disease incidence reduction, though this increase was not statistically significant. These results confirm that both SSF and T. atroviride can partially suppress F. oxysporum, but further optimization is needed for consistent and complete pathogen control.
Back to Publications



